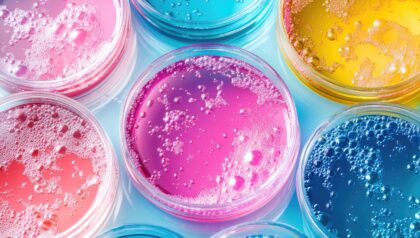

Ab 3 Jahren. Die dünne Haut einer Seifenblase schwebt als fragile Luftkugel schillernd und lautlos durch die Luft. Beim genaueren Betrachten dieses runden Gebildes lassen sich alle Farben darin finden, bis es plötzlich zerplatzt. Gestalten Sie heute mit den Kindern leuchtende Porträts von Seifenblasen.
Starten Sie jetzt Ihren kostenlosen Test und entdecken Sie das volle Potenzial des PRO Kita Portals: